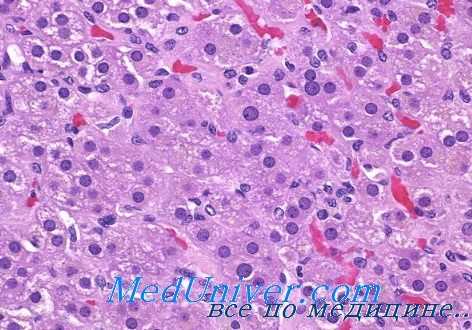
острая недостаточность коры надпочечников

Морфология острой недостаточности коры надпочечников. Патологическая анатомия синдрома Ватерхайза — Фридрихсена
Добавил пользователь Валентин П. Обновлено: 30.12.2025
Морфология хронической недостаточности коры надпочечников. Патологическая анатомия туберкулеза надпочечников
Наиболее частой причиной возникновения хронической надпочечниковой недостаточности, как отмечают многие авторы (Т. Addison, М. К. Даль, G. Ackerman, J. Taequement, L. Pignide, Г. С. Зефирова, Н. Э. Агапеева, И. В. Афанасьев и др.), является туберкулезное поражение обоих надпочечников. Туберкулез надпочечников чаще всего развивается вследствие гематогенного метастазирования инфекции в период первичного туберкулезного процесса.
Значительно реже причиной возникновения данного заболевания является врожденная гипоплазия надпочечников с явными признаками недоразвития. Иногда хроническая надпочечниковая недостаточность возникает как результат остаточных явлений после тромбозов и массивных кровоизлияний, после разрушения корковой части надпочечников злокачественной опухолью (как первичной, так и метастатического характера), а также вследствие различной этиологии воспалительных процессов (И. Б. Хавин).
Исключительно редко хроническую надпочечниковую недостаточность может вызывать также сифилис. Согласно наблюдениям В. К. Фрейдкова, причиной заболевания является первичная атрофия надпочечников.
Известны случаи, когда при болезни Аддисона в корковом слое надпочечников не наблюдалось никаких признаков патологических изменений. Однако при этом отмечались заметные атрофические, дистрофические и склеротические изменения в узлах солнечного сплетения, а также в нервных ветвях, идущих к надпочечникам. Г. С. Зефирова наблюдала случаи развития аддисоновой болезни в результате длительной недостаточности выработки передней долей гипофиза адренокортикотропного гормона.

При туберкулезном поражении надпочечников чаще всего специфический процесс имеет казеозно-некротический характер. Фиброзно-продуктивные формы туберкулеза коркового слоя надпочечников в клинической практике встречаются значительно реже. Характер изменений в значительной степени зависит от стадии процесса и степени поражения. Наиболее часто внепший вид надпочечников почти не изменен. Под капсулой иногда имеются множественные точечные кровоизлияния темно-бурого оттенка.
Ткань надпочечников при аддисоновой болезни обычно мягкой или эластической консистенции. На разрезе хорошо кон-турируется корковое и мозговое вещество, причем корковый слой обычно несколько истончен и нередко содержит мельчайшие белесоватого оттенка включения.
При хронической надпочечниковой недостаточности, возникшей в результате туберкулезного процесса, на месте надпочечников, как отмечает P. Guttman, иногда обнаруживаются лишь отдельные белесоватые рубцы, среди которых можно отметить отдельные желтовато-бурые очажки коркового и мозгового вещества.
При микроскопическом исследовании пораженных надпочечников среди клеток коркового слоя обнаруживаются очаги казеозного некроза, окруженные специфической грануляционной тканью. Среди грануляционной ткани встречается большое количество эпителиоидных клеток, а также типичные многоядерные клетки Пирогова — Лангхапса. Если очаги казеозного распада петрифицируются либо подвергаются фиброзу, надпочечники сморщиваются, уплотняются и заметно уменьшаются.
Синдром Уотерхауза-Фридериксена
Молниеносная менингококкемия, или синдром Уотерхауза-Фридериксена, представляет собой менингококцемию с явлениями сосудодвигательного коллапса и шока. Это наиболее тяжелая, прогностически крайне неблагоприятная форма менингококковой инфекции. По существу она представляет собой инфекционно-токсический шок. Она встречается у 10-20% больных с генерализованной менингококковой инфекцией и часто кончается летально.
Что провоцирует / Причины Синдрома Уотерхауза-Фридериксена:
Возбудителем менингококковой инфекции является грамотрицательный диплококк Neisseria meningitidis, высокочувствительный к факторам внешней среды: погибает при перепадах температуры, влажности, интенсивности солнечной радиации, прихотлив к условиям культивирования. Вне организма сохраняет жизнеспособность не более 30 мин. Известно 13 серотипов возбудителя. Эпидемиологическое значение в Украине имеют серотипы А, В, С. Изредка встречаются полиагглютинирующие штаммы. При прямой микроскопии крови и ликвора возбудитель обнаруживается внутри- и внеклеточно в виде парно располагающихся кокков в форме кофейных зерен. В клеточной оболочке микроба имеется липополисахарид, отвечающий за эндотоксиноподобное действие при менингококковом сепсисе.
Эпидемиология
В большинстве развитых стран распространенность менингококковой инфекции составляет 1-3 случая на 100 тыс. населения, встречается в любом возрасте, однако 70-80% приходится на детей до трех лет. Наиболее подвержены развитию гипертоксических (сверхострых) форм инфекций дети первых трех лет, особенно первого года жизни.
Характерны эпидемиологические подъемы заболеваемости каждые 10-20 лет, что связано со сменой возбудителя и изменением иммунологической структуры населения (увеличение восприимчивой прослойки за счет родившихся детей, снижения иммунитета у взрослых). Также имеют место сезонные подъемы заболеваемости (март-апрель-май), хотя больные этой инфекцией регистрируются в течение всего года.
Источником заболевания является больной или бактерионоситель. Механизм передачи – воздушно-капельный. Наиболее заразны больные с катаральными явлениями со стороны носоглотки. Здоровые носители также имеют эпидемиологическое значение, так как их количество в сотни раз превышает число больных. Известно, что предвестником очередного подъема заболеваемости является нарастание числа носителей менингококка. В детских коллективах заражению детей способствует тесный длительный контакт в помещении, особенно в спальных комнатах. Восприимчивость к менингококку достаточно высокая. Но особенность состоит в том, что характерная клиническая картина наблюдается лишь у 0,5% инфицированных. Крайне редко встречается семейная предрасположенность к менингококковой инфекции. В этих семьях наблюдались случаи заболевания менингококцемией и менингитом разных детей в разное (с промежутком в несколько лет) время, а также повторные случаи заболевания у одного из этих детей.
Летальность детей первого года жизни наиболее высокая. Основная причина – сверхострый менингококковый сепсис с развитием инфекционно-токсического шока (ИТШ), а также тяжелый гнойный менингит, осложненный отеком-набуханием головного мозга. Большое влияние на исход заболевания имеют своевременность диагностики, своевременность и правильность начатого лечения.
Патогенез (что происходит?) во время Синдрома Уотерхауза-Фридериксена:
Синдром Уотерхауса – Фридериксена, как и первичная хроническая недостаточность коры надпочечников, связан с разрушением коры. Поскольку деструктивный процесс в этом случае протекает интенсивнее (обычно это кровоизлияние в надпочечники, реже острая ишемия), синдром недостаточности надпочечников развивается внезапно, без предшествующей стадии хронического дефицита кортикостероидов. Патогенез классического синдрома Уотерхауса – Фридериксона, возникающего на фоне тяжелой, остро текущей (обычно септической) инфекции, окончательно не выяснен. Высказывается мнение, что этот синдром является частным случаем так называемого общего адаптационного синдрома, т.е. следствием тяжелого сепсиса, вызывающего перенапряжение и истощение адаптационных гипофизарно-адреналовых механизмов. Такая точка зрения подтверждается тем, что во многих случаях типичного (по этиологии и клинической картине) синдрома Уотерхауса – Фридериксена в надпочечниках отсутствуют анатомические изменения. По-видимому, таков же механизм развития острой надпочечниковой недостаточности у новорожденных в процессе осложненных родов или у беременных с тяжелым токсикозом, но не исключено, что во всех рассматриваемых случаях этот синдром является следствием каких-то других механизмов.
Если рассматривать синдром Уотерхауса – Фридериксена как стадию истощения общего адаптационного синдрома, то, очевидно, сюда же следует отнести и аддисонический криз, развивающийся иногда во время тяжелых соматических заболеваний, обширных травм или сложных хирургических вмешательств. Адаптивная роль гипофизарно-адреналовой системы в формировании ответных реакций на воздействие экзогенных факторов установлена и общепризнана. В соответствии с теорией общего адаптационного синдрома при длительном воздействии неблагоприятных (стрессовых) факторов развивается стадия истощения, которая сопровождается снижением функции надпочечников и морфологическими изменениями в их корковом слое (Селье, 1960). Многочисленные клинические исследования подтвердили, что функция коры надпочечников снижается при тяжелых нагноительных заболеваниях, туберкулезе легких, язвенной болезни желудка и двенадцатиперстной кишки, злокачественных опухолях, пороках сердца и др.
Симптомы Синдрома Уотерхауза-Фридериксена:
Заболевание начинается неожиданно и часто уже через несколько часов больной находится в глубокой прострации. Быстро поднимается температура, отмечается озноб. В течение нескольких часов на теле появляются многочисленные петехии и кровоподтеки, кожа местами приобретает окраску, напоминающую трупные пятна. Петехии и элементы пурпуры скоро увеличиваются, при этом вероятны обширные подкожные кровоизлияния. В начале заболевания, до наступления шока, отмечается генерализованный спазм сосудов; сознание больного светлое, он бледен, губы у него синюшные, руки и ноги холодные на ощупь. Менингеальный синдром, как правило, бывает выражен даже в тех случаях, когда ликвор остается неизмененным. В крови высокий гиперлейкоцитоз с резким нейтрофильным сдвигом. Артериальное давление прогрессивно падает. Пульс частый, еле уловимый, вскоре перестает прощупываться. Усиливаются цианоз, головокружение, рвота (часто кровавая), судороги. Нарастает одышка. Больные впадают в быстро прогрессирующую прострацию с потерей сознания. Нарушение солевого и углеводного обмена, выделения 17-кетостероидов и другие симптомы, которые могли бы внести ясность в патогенез заболевания, при острой недостаточности надпочечников не успевают развиться. При отсутствии активной заместительной гормональной терапии развивается кома и в течение 16-30 часов от начала болезни наступает смерть. Внезапная смерть является следствием остро развившейся недостаточности надпочечников. На вскрытии находят резкое полнокровие надпочечников и кровоизлияния в них. Кровоизлияние в надпочечники служит в последние годы самой частой непосредственной причиной смерти при менингококковом сепсисе. Реже наблюдается атрофия надпочечников, также приводящая к развитию острой недостаточности.
При наступлении шока больной впадает в коматозное состояние, у него уменьшается сердечный выброс и снижается артериальное давление. Если начинающийся шок не распознается и не назначается в неотложном порядке подходящее лечение, почти неизбежен летальный исход в результате сердечной и/или дыхательной недостаточности. В период выздоровления у больного можно наблюдать обильное шелушение в местах высыпаний или утрату пальцев в результате гангрены.
В отсутствие рациональной терапии больные погибают в первые часы и сутки болезни от острой сердечно-сосудистой или острой почечной недостаточности.
Диагностика Синдрома Уотерхауза-Фридериксена:
Диагноз всех форм менингококковой инфекции базируется на комплексе данных, полученных эпидемиологическим, анамнестическим и клиническим методами, и окончательно устанавливается с помощью лабораторных исследований. Отдельные методы имеют неодинаковую диагностическую ценность при различных клинических формах менингококковой инфекции. Так, диагноз менингококковыделительства возможен лишь при использовании бактериологического метода, когда материалом для изучения является слизь проксимальных отделов верхних дыхательных путей.
В диагностике менингококкового назофарингита главное место занимают эпидемиологический и бактериологический методы, так как клинически разграничить менингококковый назофарингит от другого генеза невозможно или крайне трудно.
В распознавании генерализованных форм реальную диагностическую ценность приобретает анамнестический и клинический методы диагностики, особенно при сочетании менингококкемии и менингита. В диагностике менингита большое значение имеет исследование цереброспинальной жидкости.
При генерализованных формах менингококковой инфекции окончательный диагноз верифицируется бактериологическим методом.
Из иммунологических методов наиболее чувствительны и информативны РНГА, ИФА.
Лечение Синдрома Уотерхауза-Фридериксена:
Терапевтическая тактика при менингококковой инфекции зависит от клинической формы, тяжести течения заболевания, наличия осложнений, преморбидного фона.
Профилактика Синдрома Уотерхауза-Фридериксена:
При установлении диагноза менингококковой инфекции о каждом случае подается экстренное извещение в районную или городскую СЭС. В детском учреждении устанавливается карантин на 10 дней с момента изоляции последнего больного. Проводится бактериологическое исследование (мазок из носоглотки) контактных с носителем по месту жительства и в детском учреждении. За контактными детьми в детском учреждении устанавливается наблюдение: ежедневный осмотр кожных покровов, слизистой зева, термометрия. Им назначается рифампицин на 2 дня в возрастной дозировке.
К каким докторам следует обращаться если у Вас Синдром Уотерхауза-Фридериксена:
Вас что-то беспокоит? Вы хотите узнать более детальную информацию о Синдрома Уотерхауза-Фридериксена, ее причинах, симптомах, методах лечения и профилактики, ходе течения болезни и соблюдении диеты после нее? Или же Вам необходим осмотр? Вы можете записаться на прием к доктору .
Морфология острой недостаточности коры надпочечников. Патологическая анатомия синдрома Ватерхайза — Фридрихсена
Морфология адрено-генитального синдрома. Патологическая анатомия первичного гиперкортицизма
Этот синдром включает в себя ряд клинических проявлений, связанных с повышенной продукцией корковым слоем надпочечников стероидных гормонов (17-кетостероидов), с андрогенным и значительно реже острогенным действием. В этиологии адрено-генитального синдрома основная роль принадлежит генетическим факторам, что подтверждается возникповениом данного синдрома у представителей одной семьи. Этим заболеванием страдают как мужчины, так и женщины любого возраста. Нередки случаи адрено-генитального синдрома у детей, особенно в препубертатном периоде.
Наиболее частой причиной развития адрено-генитального синдрома является врожденная гиперплазия коры надпочечников. Обычно такая патология приводит к возникновению псевдогермафродитизма. Время начала андрогенной секреции в коре надпочечников определяет различия в строении наружных половых органов. Чем раньше начинается гиперсекреция в коре надпочечников, тем отчетливее проявляются признаки псевдогермафродитизма. Изменения в половой сфере иногда сопровождаются синдромом солевого истощения и гипертонией. Врожденная гиперплазия коры надпочечников чаще встречается у девочек и приводит к псевдогермафродитизму, у мальчиков обычно развивается преждевременная вирилизация.
Сведения о патологоанатомических изменениях при врожденной гиперплазии коры надпочечных желез очень немногочисленны, так как такие больные довольно рано подвергаются интенсивному лечению, которое в значительной степени изменяет первоначальную картину патологического процесса. Обычно при врожденной гиперплазии коры надпочечников увеличиваются в весе надпочечные железы. При гистологическом исследовании коркового слоя определяется гиперплазия сетчатой зоны. Пучковая зона у детей или обычных размеров, или слегка расширена, а у взрослых, наоборот, сужена. Эпителиальные клетки сетчатой зоны содержат много липидов и пигмента, в клетках же пучковой зоны липиды отсутствуют, а их протоплазма интенсивно окрашивается эозином.
У новорожденных детей с признаками псевдогермафродитизма Blakmann также отмечал увеличение в весе надпочечных желез, а гистологически между пучковой и пренатальной сетчатой зоной — тонкий слой клеток, напоминающих клетки сетчатой зоны взрослого человека. С увеличением возраста ребенка этот слой клеток значительно расширяется. Клубочковая зона иногда не изменяется, а у больных с сольтеряющим синдромом нередко отсутствует. При исследовании других органов выявлена узелковая гиперплазия лейдиговских клеток яичка, в ряде случаев клетки Лейдига отсутствуют. У больных раннего юношеского возраста могут обнаружиться признаки сперматогенеза.

В яичниках значительно уменьшается количество фолликулов, образуются маленькие кисты и отмечается гиперплазия клеток в области ворот. В передней доле гипофиза увеличивается количество базофилов, появляются огромные клетки с пенистой цитоплазмой.
Как было указано выше, клинические проявления адрено-генитального синдрома в значительной степени обусловливаются гиперсекрецией андрогенов, продуцируемых клетками сетчатой зоны коры надпочечников. Однако отмеченная гиперсекреция может наблюдаться не только при врожденной гиперплазии коры, а и в результате развития гормональноактивной опухоли этого органа.
Адрено-генитальный синдром иногда развивается у больных с гормональноактивными опухолями яичников. К таким новообразованиям относятся андробластомы, липоидноклеточные вирилизирующие опухоли яичников, характеризующиеся нередко злокачественным течепием (см. гормональноактивные опухоли женских половых желез).
Если патологические изменения в корковом слое надпочечников развиваются в эмбриональном периоде, то они приобретают преимущественно врожденный гиперпластический характер, при нарушениях же в постнатальном периоде — явно опухолевый. На развитие клинической симптоматики, вызванпой патологическими изменениями в пучковой и сетчатой зонах надпочечников, влияет пол и возраст больного.
Адрено-генитальный синдром может наблюдаться в любом возрасте, однако наиболее выраженные и тяжелые изменения бывают при развитии заболевания в препубертатном периоде. Так, у мальчиков основным клиническим призпаком развития адреногенитального синдрома, как отмечают Е. И. Тараканов, R. Williams, а также Г. П. Шульцев, Г. В. Брагин и О. Б. Шныренкова, является преждевременное половое созревание, у девочек — возникновение отчетливых признаков вирилизации.
При врожденной вирилизирующей гиперплазии коркового слоя надпочечников нередко могут развиваться различные формы псевдогермафродитизма. Однако у больных женщин иногда единственным признаком псевдогермафродитизма могут быть явления вирилизации (Е. З. Гинчерман, Ф. М. Эгарт, 1961; Л. Л. Либерман, А. М. Раскин).
У взрослых мужчин признаком адрено-генитального синдрома чаще всего является феминизация организма (Л. Соффер, Р. Дорфман, Л. Габрилав).
Злокачественные инсуломы. Морфология опухолей островков Лангерханса
Злокачественные аналоги инсулом обычно достигают значительных размеров и локализуются в хвостовой части, редко — в теле и головке поджелудочной железы. Единственным доказательством злокачественного перерождения инсуломы является наличие метастазов. Однако даже при гистологическом исследовании материала поставить диагноз злокачественного новообразования островков поджелудочной железы трудно.
По внешнему виду злокачественные опухоли, растущие из островковои паренхимы, очень папоминают раковые образования поджелудочной железы неинсулярного происхождения. На разрезе такие опухоли серого или розового цвета, плотной, иногда пластической консистенции, без четких границ с окружающей неизмененной паренхимой поджелудочной железы. Как и доброкачественные инсуломы, карциноматозные процессы этого органа чаще всего развиваются из тела или хвоста, значительно реже — из добавочных поджелудочных желез.
При микроскопическом исследовании злокачественные формы инсулом напоминают аденокарциномы. Несомненным критерием злокачественности инсулом служит наличие выраженного инфильтративного роста эпителиальных элементов. Они сравнительно рано метастазируют по лимфатическим путям в регионарныо лимфатические узлы, печень, легкие и другие внутренние паренхиматозные органы. Основными морфологическими проявлениями малигнизации инсуломы считается клеточная анаплазия и атипия, множественные метастазы, прорастание опухолевыми эпителиальными элементами капсулы и окружающих тканей (К. А. Горнак, Ф. Г. Углов), наличие участков некроза.
Соотношение паренхимы и стромы в злокачественной инсуломе обычно такое же, как при простом раке или скирре поджелудочной железы.

Следует отметить, что в некоторых случаях, несмотря на выраженные признаки гипогликемической болезни, хирург не находит опухолевидного образования в поджелудочной железе. При гистологическом исследовании кусочков ткани, взятых из различных участков железы, обнаруживаются признаки диффузной гиперплазии клеточных элементов инсулярного аппарата (М. Sendrail, D. Douglas, Petit, J. Levi, L. Leger, О. В. Николаев, З. Г. Вейнберг).
При тяжелых формах гиперинсулинизма поражается главным образом центральная нервная система. Патоморфологические изменения в этой системе носят примерно такой же характер, как и при аноксии. В сером и белом вещество головного мозга отмечается застойное полнокровие, иногда стаз в кровеносных сосудах, петехиальные кровоизлияния, диффузные и очаговые геморрагии, признаки набухания, вакуолизации ядер ганглиозных клеток, поражение корковых невронов.
В остальных случаях, как отмечает А. П. Аносова, при гиперинсулиновом синдроме поражаются вегетативные отделы центральной нервной системы, мозжечок, ядра гипоталамической области, а также отдельные участки продолговатого мозга.
Острая надпочечниковая недостаточность чаще всего возникает у больных в результате оперативного удаления одного из пораженных надпочечников по поводу наличия гормональноак-тивной опухоли в корковом слое. Нередко причиной острой недостаточности коркового вещества надпочечников являются массивные диффузные кровоизлияния в обе надпочечниковые железы у новорожденных в момент патологических родов. Значительно реже острая надпочечниковая недостаточность может возникнуть в результате кровоизлияний в надпочечники у лиц с наследственным сифилисом, а также у беременных женщин в период токсикоза и особенно эклампсии.
При гормональноактивной опухоли в одном из надпочечников (вследствие постоянно повышенной концентрации в крови гормонов коркового вещества) постепенно развивается атрофия второго надпочечника. Поэтому при хирургическом удалении такой опухоли следует ожидать появления острой надпочечниковой недостаточности, а в ряде случаев — и надпочечниковой комы (В. А. Кованев).
Состояние острой недостаточности коркового вещества надпочечников может возникнуть также в результате неправильно проводимой гормональной терапии. Чрезмерно длительное введение гормонов коры надпочечников (глюкокортикоидов) или применение их в больших дозах приводит к компенсаторному ослаблению гормонообразования в надпочечных железах, а иногда и к почти полному прекращению их функциональной деятельности. Следовательно, после внезапного прекращения введения больным кортикостероидпых препаратов может, как отмечают В. Е. Волков, М. Юлес, И. Холло, также наступить острая надпочечниковая недостаточность.
Несколько реже возникает клиническая картина адренокортикального криза вследствие острого нарушения кровоснабжения надпочсчпиковых желез, тромбоза вен или множественных очаговых или диффузных кровоизлияний. Обширные апоплексические очаги в обоих надпочечниках нередко бывают у детей раннего возраста при синдроме Ватерхайза — Фридрихсена, вызванном менингококковой септицемией (G. Schroder, Н. Martland, Н. М. Коврижко, Н. А. Гавриков).
Иногда при этом синдроме наблюдаются множественные мелкие геморрагические некрозы в сетчатой и несколько реже пучковой зонах надпочечников. Клубочковая зона коры надпочечников, а также мозговое вещество при острой надпочечниковои недостаточности почти никогда не подвергаются патологическим изменениям.
Некоторые авторы считают, что причиной острой надпочечниковой недостаточности может быть острый геморрагический воспалительный процесс в этих железах, иногда клинически протекающий по типу панкреатита. При этом в кожных покровах, а также во внутренних паренхиматозных органах обнаруживаются множественные петехиальные кровоизлияния. В коже при острой падпочечниковой недостаточности можно наблюдать диффузно распространенные деструктивные изменения капилляров и мелких артериол вследствие бактериальных эмболии.
Надпочечниковая же кома нередко развивается на фоне хронической либо скрытой надпочечниковой недостаточности при обострении заболевания, вызванном любыми неблагоприятными факторами. Коматозное состояние возникает чаще внезапно и характеризуется резкой слабостью и всеми признаками коллапса. Иногда коматозное состояние сопровождается рядом неврологических симптомов, а также сильными болями в области живота (Г. С. Зефирова, В. Е. Волков, Н. А. Салайда).
При аддисоновой болезни острая надпочечниковая недостаточность может возникнуть в связи с перенесенными психическими потрясениями, чрезмерной физической нагрузкой, наконец, в результате оперативного вмешательства, предпринятого по поводу любого интеркуррентного заболевания.
Одним из факторов, способствующих переходу хронической надпочечниковой недостаточности в острую, может явиться ограничение или резкий недостаток натрия в пище, либо избыток в ней калия.
При патологоанатомическом исследовании оставшегося надпочечника у лиц, умерших от коллапса или адренокортикальной комы вследствие оперативного удаления опухоли другого надпочечника, наблюдаются выраженные дистрофические и атрофические изменения в клетках сетчатой и пучковой зон. Вес такого надночечника, как правило, уменьшен, определяется диффузная его атрофия, а в корковом слое обнаруживаются множественные воспалительные инфильтраты и очаги кровоизлияний. На месте старых воспалительных инфильтратов разрастается грубоволокнистая соединительная ткань, образующая со временем плотные рубцы, замещающие функционирующую паренхиму коркового слоя надпочечников.
Указанные патологические изменения в исключительно редких случаях распространяются также и на мозговое вещество надпочечников.
При различных инфекционных заболеваниях, осложняющихся острой надпочечниковой недостаточностью, в корковом слое могут образовываться множественные точечные геморрагии, воспалительные инфильтраты, а также наблюдаются дистрофические изменения в клетках сетчатой и пучковой зон, сопровождающиеся пикнозом ядер и исчезновением из протоплазмы липоидов. В этих случаях обнаруживаются тромбозы синусоидальных сосудов, иногда дегенеративные изменения с участками некроза без признаков геморрагии.
При острых инфекционных заболеваниях, вызванных менинго-кокковым и стрептококковым возбудителями, сопровождающихся сосудистым коллапсом, в корковом слое надпочечников можно отметить обширные геморрагические некрозы, а в паренхиме сетчатой и пучковой зон — признаки экссудативного воспаления с примесью полипуклеарных лейкоцитов и фибрина. Нередко к описанному состоянию присоединяются явления острого миокардита. В остальных внутренних паренхиматозных органах наблюдаются патологические изменения, характерные для острого сепсиса.
Острая недостаточность коркового вещества надпочечников, заканчивающаяся внезапной смертью больного, чаще всего обусловливается тимико-лимфатическим статусом. При этом может сохраняться неизмененной или даже несколько гипертрофированной зобная железа, а также наблюдаться явления гиперплазии лимфатических узлов и лимфоидных фолликулов белой пульпы селезенки.
Читайте также:
- Сложные эпителии. Многослойный эпителий. Переходной эпителий. Железистый эпителий.
- Симптомы подскладочного стеноза гортани у новорожденного и его лечение
- Дифференциальная диагностика, лечение злокачественной зернистоклеточной опухоли.
- Изучение ушного шума - учения о шуме
- Ревматизм при пороках сердца. Аномалия развития сердца
